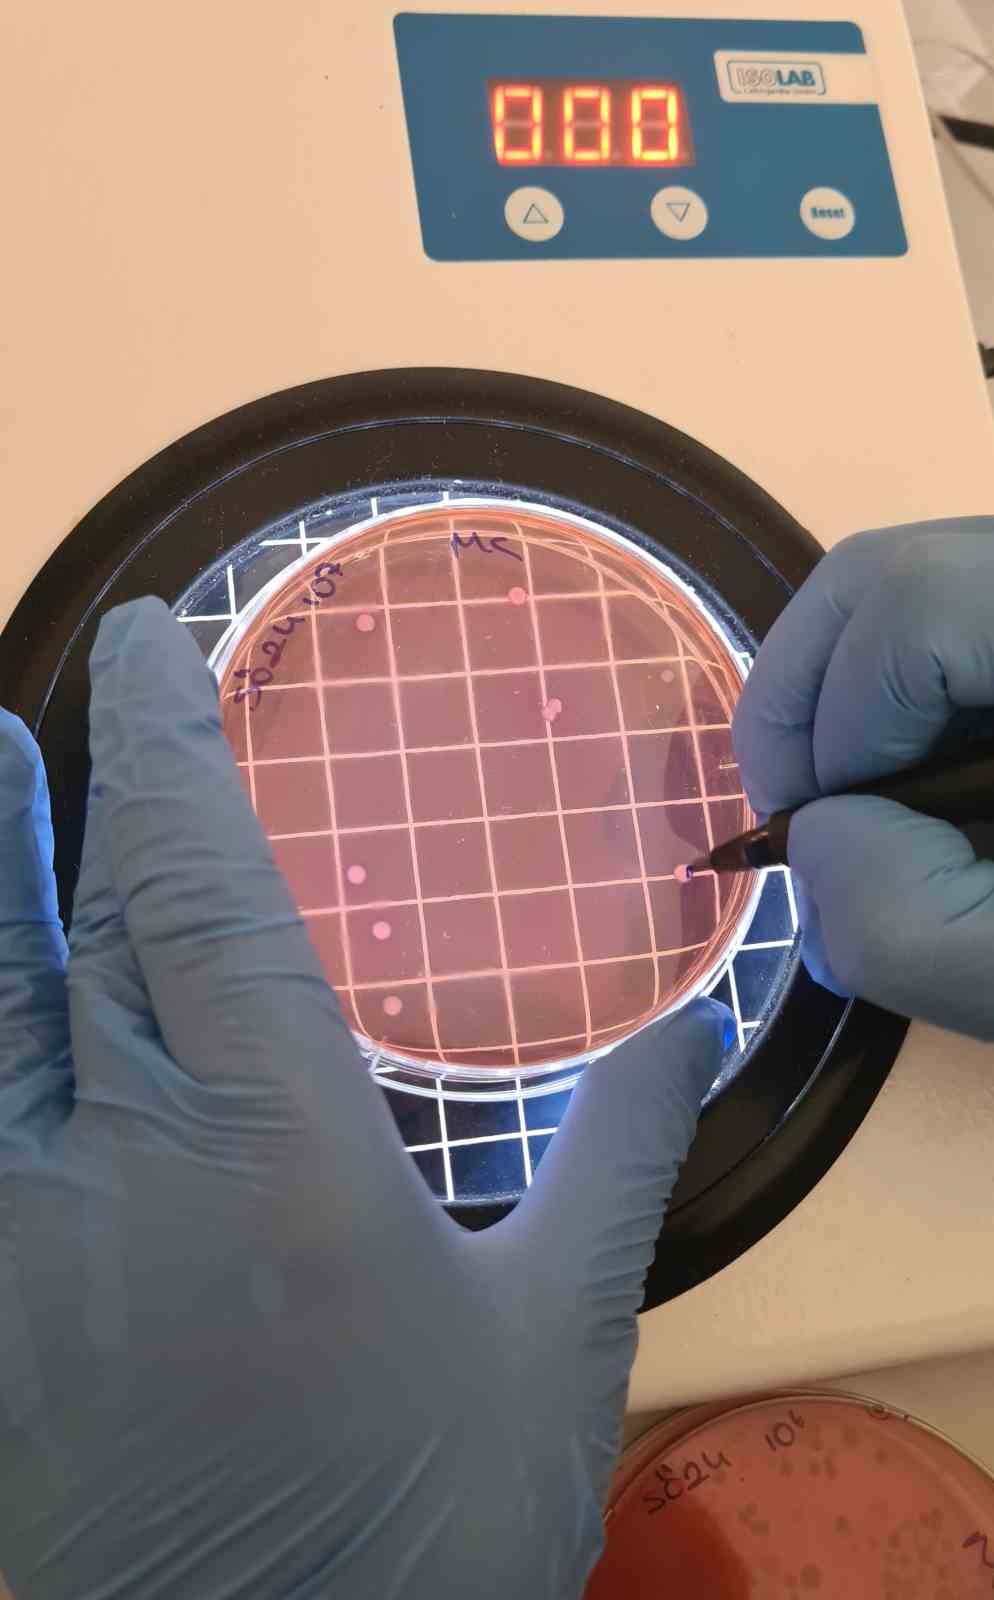
20251128Aw588590 6

İnönü Üniversitesi Fen-Edebiyat Fakültesi Biyoteknoloji Anabilim Dalı tarafından yürütülen kapsamlı bir çalışma, çiğ sütün yalnızca bilinen hijyen riskleri taşımadığını; aynı zamanda idrar yolu enfeksiyonlarına neden olabilen özel bakteri suşlarını da barındırdığını ortaya çıkardı.
Malatya kırsalından toplanan 122 çiğ süt örneği üzerinde yapılan incelemeler, sütün adeta “görünmeyen bir bakteri ekosistemi” gibi davrandığını ve bu yapıdaki bazı bakterilerin sessizce üriner sisteme ulaşarak enfeksiyon oluşturabildiğini gösterdi.
Bilimsel Araştırma Projeleri (BAP) Birimi destekli “Çiğ Süt Örneklerinde Escherichia coli Prevalansı ve Üropatojenik E. coli (UPEC) Virülans Genlerinin Araştırılması” başlıklı proje, bölgede toplanan süt örneklerinde E.coli oranının düşündüğünden daha yüksek olduğunu, üstelik bu bakterilerin hatırı sayılır bir kısmında UPEC suşlarına özgü genetik yapıların bulunduğunu tespit etti.
![]()
“SADECE BAKTERİSİ VAR MI DİYE BAKMAK BÜYÜK EKSİKLİK”
Araştırmayı yöneten Doç. Dr. Seval Cing Yıldırım, yıllardır uygulanan klasik denetim anlayışının artık yetersiz kaldığını belirtti. Yıldırım’a göre, sadece bakteri varlığını ölçmek değil, o bakterilerin hastalık yapıcı özelliklerini ve taşıdığı virülans genlerini belirlemek gerekiyor.
DOÇ. DR. YILDIRIM ŞU DEĞERLENDİRMEYİ YAPTI:
“Çiğ sütlerde tespit ettiğimiz izolatların büyük bölümü, idrar yolu enfeksiyonlarında rol oynayan UPEC suşlarının fimA ve agn43 gibi kritik genlerini taşıyor. Bu genler bakterilere idrar yollarına yapışma, biyofilm oluşturma ve bağışıklık sisteminden kaçma gibi oldukça güçlü özellikler kazandırıyor. Yani çiğ süt, sanılandan çok daha karmaşık bir bakteri ağına ev sahipliği yapıyor.”
Araştırma verileri, süt aracılığıyla alınan bu bakterilerin özellikle kadınlar, yaşlı bireyler ve bağışıklığı baskılanmış kişilerde enfeksiyon riskini artırdığını gösteriyor.
ANTİBİYOTİK DİRENCİ UYARISI: “DİRENÇ ÇİFTLİKTE SEÇİLİYOR, SOFRAYA GERİ DÖNÜYOR”
Doç. Dr. Yıldırım’ın en dikkat çekici uyarılarından biri de antibiyotik direnci konusunda oldu. İncelenen tüm örneklerde sefalotin başta olmak üzere birçok antibiyotiğe karşı direnç saptandı. Araştırmacıya göre bu durum, gıda güvenliği için yeni bir alarm niteliğinde:
“Dirençli bakteriler hayvancılık ortamında seçiliyor ve gıda zinciri aracılığıyla insanlara geri dönüyor. Çoklu antibiyotik direnci artık tarım ve hayvancılık sisteminin kaçınılmaz bir sonucu olarak karşımıza çıkıyor. Bu yüzden rutin kontrollerde moleküler patojenite analizleri ve direnç taramalarının yer alması bir zorunluluk haline geldi.”
Yıldırım ayrıca, pastörizasyonun büyük ölçüde etkili olduğunu fakat süt üretiminin her aşamasında hijyen sağlanmadıkça riskin sıfırlanamayacağını vurguladı. Özellikle çiğ sütten yapılan ve kısa süreli ısıl işlem gören peynirlerde dirençli bakterilerin yaşamaya devam edebildiğini ifade etti.
![]()
“AMACIMIZ KORKUTMAK DEĞİL, BİLİMSEL FARKINDALIK OLUŞTURMAK”
Doç. Dr. Yıldırım, çiğ sütle ilgili bulguların toplumda paniğe yol açmaması gerektiğini; ancak bu verilerin gıda güvenliği politikalarının güncellenmesi için önemli bir fırsat sunduğunu dile getirdi:
“Sütün doğal bir ürün olması onun mikrobiyolojik açıdan güvenli olduğu anlamına gelmez. Biz korku üretmek istemiyoruz, ancak bilimsel veriler ışığında toplumun bilinçlenmesini sağlamamız gerekiyor. Doğru ısıl işlem, hijyen ve moleküler denetimlerle süt ve süt ürünleri elbette güvenle tüketilebilir.”

122 ÇİĞ SÜT ÖRNEĞİ ALTI AYDA TOPLANDI
Araştırma ekibinde yer alan yüksek lisans öğrencisi Aynur Akan ise 122 çiğ süt örneğinin altı aylık süreçte Malatya’nın farklı kırsal bölgelerinden toplandığını belirtti. Laboratuvar çalışmalarının bir kısmının İnönü Üniversitesi’nde, diğer kısmının ise Sinop Üniversitesi’ndeki akademisyenlerle ortak yürütüldüğünü aktardı.
Akan, projeye destek veren BAP Birimi’ne teşekkür ederek, bu çalışmanın Türkiye’de çiğ sütle ilgili riskleri bilimsel açıdan daha görünür kıldığını ifade etti.




